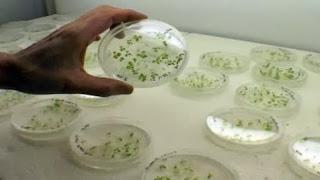
Su Rai 3 una nuova puntata di

Lunedì 11 novembre alle 21.15 su Rai 3 va in onda una nuova puntata di "Report". In questo numero:
Lunedì 11 novembre alle 21.15 su Rai 3 va in onda una nuova puntata di "Report". In questo numero:
“L'INSOSTENIBILE BREVETTO” Di Piero Riccardi “ ...Per fare un tavolo ci vuole un albero,...per fare un fiore ci vuole un seme”, così cantava Sergio Endrigo, riprendendo una filastrocca di Gianni Rodari. Era il 1973. Un anno dopo due ricercatori americani, Watson e Crick, presentavano al mondo l’elica del Dna. Così, se Endrigo quella filastrocca la cantasse oggi, dovrebbe dire che per fare un seme ci vuole un brevetto. Un viaggio inchiesta nell’intreccio che lega industria chimica e semi coperti da copyright. Secondo uno studio della Fao, negli anni ‘70, c’erano 7000 compagnie sementiere e nessuna superava l’1% del mercato mondiale. Oggi, le prime tre compagnie detengono il 53%, le prime dieci il 76% e tra queste sei coprono ben il 75% del mercato planetario dei pesticidi. Numeri che rivelano già l’intreccio indissolubile tra chi produce semi e chi produce i veleni per le erbe indesiderate. Ma tutto questo è sostenibile? E fino a quando? E soprattutto ci sono alternative?.
 “AAA. PATRIMONIO SVENDESI”
Di Giorgio Mottola
Perfino i giornali stranieri invitano i più facoltosi a mettere le mani su parti del patrimonio italiano, perché conviene. E così si sono organizzati: ci sono agenzie immobiliari che hanno inviato i loro manager nel Chianti per vendere casali e castelli principeschi con annesso panorama mozzafiato. A Rovigo si è addirittura costituita un’associazione per facilitare l’acquisto ai Russi di parti del nostro Paese. E così a Pisa sono arrivati decine di magnati russi per comprare il porto, una serie di Hotel e una quarantina di immobili dal valore monumentale.
“AAA. PATRIMONIO SVENDESI”
Di Giorgio Mottola
Perfino i giornali stranieri invitano i più facoltosi a mettere le mani su parti del patrimonio italiano, perché conviene. E così si sono organizzati: ci sono agenzie immobiliari che hanno inviato i loro manager nel Chianti per vendere casali e castelli principeschi con annesso panorama mozzafiato. A Rovigo si è addirittura costituita un’associazione per facilitare l’acquisto ai Russi di parti del nostro Paese. E così a Pisa sono arrivati decine di magnati russi per comprare il porto, una serie di Hotel e una quarantina di immobili dal valore monumentale.
 E a proposito di patrimoni svenduti, “Report” è tornato a Carrara per occuparsi delle cave:
“L’EDITTO DI CARRARA”
Di Bernardo Iovene
Le ottanta cave di Carrara sono gestite da quasi duecento imprese, la maggior parte di queste lavora senza concessione comunale. Cioè sono autorizzate in modo provvisorio. Tutto è fermo perché nel 1751 Maria Teresa, principessa di Carrara, stabilì che chi in quel momento coltivava le cave ne diventava possessore. Questo regime è durato fino al 1994, quando il sindaco Emilia Fazzi Contigli per la prima volta istituì un regolamento che prevedeva concessioni onerose e temporanee.
Ma quando fu eletto un nuovo sindaco azzerò tutto tornando al regime precedente. Oggi le cave di marmo sono autorizzate dal Comune per 29 anni rinnovabili automaticamente, e gli imprenditori pagano un prezzo stabilito in trattativa. Insomma la cittadinanza ci guadagna ben poco. E invece la legge nazionale prevede un bando di gara e il pagamento di una percentuale fissa sul prezzo di mercato. A complicare la situazione è intervenuta la Procura: sotto indagine una decina di imprenditori che avrebbero venduto i blocchi di marmo in India e Cina fatturando solo una piccola percentuale e frodando così il fisco.
E a proposito di patrimoni svenduti, “Report” è tornato a Carrara per occuparsi delle cave:
“L’EDITTO DI CARRARA”
Di Bernardo Iovene
Le ottanta cave di Carrara sono gestite da quasi duecento imprese, la maggior parte di queste lavora senza concessione comunale. Cioè sono autorizzate in modo provvisorio. Tutto è fermo perché nel 1751 Maria Teresa, principessa di Carrara, stabilì che chi in quel momento coltivava le cave ne diventava possessore. Questo regime è durato fino al 1994, quando il sindaco Emilia Fazzi Contigli per la prima volta istituì un regolamento che prevedeva concessioni onerose e temporanee.
Ma quando fu eletto un nuovo sindaco azzerò tutto tornando al regime precedente. Oggi le cave di marmo sono autorizzate dal Comune per 29 anni rinnovabili automaticamente, e gli imprenditori pagano un prezzo stabilito in trattativa. Insomma la cittadinanza ci guadagna ben poco. E invece la legge nazionale prevede un bando di gara e il pagamento di una percentuale fissa sul prezzo di mercato. A complicare la situazione è intervenuta la Procura: sotto indagine una decina di imprenditori che avrebbero venduto i blocchi di marmo in India e Cina fatturando solo una piccola percentuale e frodando così il fisco.
 “CUCI E TAGLIA”
Di Emilio Casalini
“Report” torna ad occuparsi anche delle sorti dell’Ittierre, la più importante azienda del fashion italiano che è di nuovo in crisi. Da sola produceva circa il 10% del pil del Molise, era entrata in crisi nel 2009, e per salvarla erano intervenuti il Governo prima e la Regione poi con una fideiussione di 12 milioni. Dopo aver speso milioni di euro pubblici, dopo due anni di amministrazione straordinaria e altrettanti di gestione privata, hanno portato i libri in tribunale. Migliaia di lavoratori, alcuni altamente specializzati, rischiano di rimanere per strada. Nell’inchiesta si prova a capire come mai una delle più prestigiose aziende del made in Italy è stata ridotta con le pezze sul sedere.
“CUCI E TAGLIA”
Di Emilio Casalini
“Report” torna ad occuparsi anche delle sorti dell’Ittierre, la più importante azienda del fashion italiano che è di nuovo in crisi. Da sola produceva circa il 10% del pil del Molise, era entrata in crisi nel 2009, e per salvarla erano intervenuti il Governo prima e la Regione poi con una fideiussione di 12 milioni. Dopo aver speso milioni di euro pubblici, dopo due anni di amministrazione straordinaria e altrettanti di gestione privata, hanno portato i libri in tribunale. Migliaia di lavoratori, alcuni altamente specializzati, rischiano di rimanere per strada. Nell’inchiesta si prova a capire come mai una delle più prestigiose aziende del made in Italy è stata ridotta con le pezze sul sedere.


![Ecco profilo digitale dello studente italiano [Infografica]](https://m22.paperblog.com/i/274/2740004/ecco-il-profilo-digitale-dello-studente-itali-L-upoQWw-175x130.jpeg)



